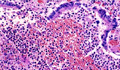

- 5.Lung, Pleura
- ★(7)Bacterial pneumonia (bronchopneumonia)
Macroscopic view (bronchopneumonia): Within the centrilobular area, separate yellowish-white foci expand and occasionally fuse. The cut surface is congested and air spaces are collapsed.
Click the image to see the enlarged image.